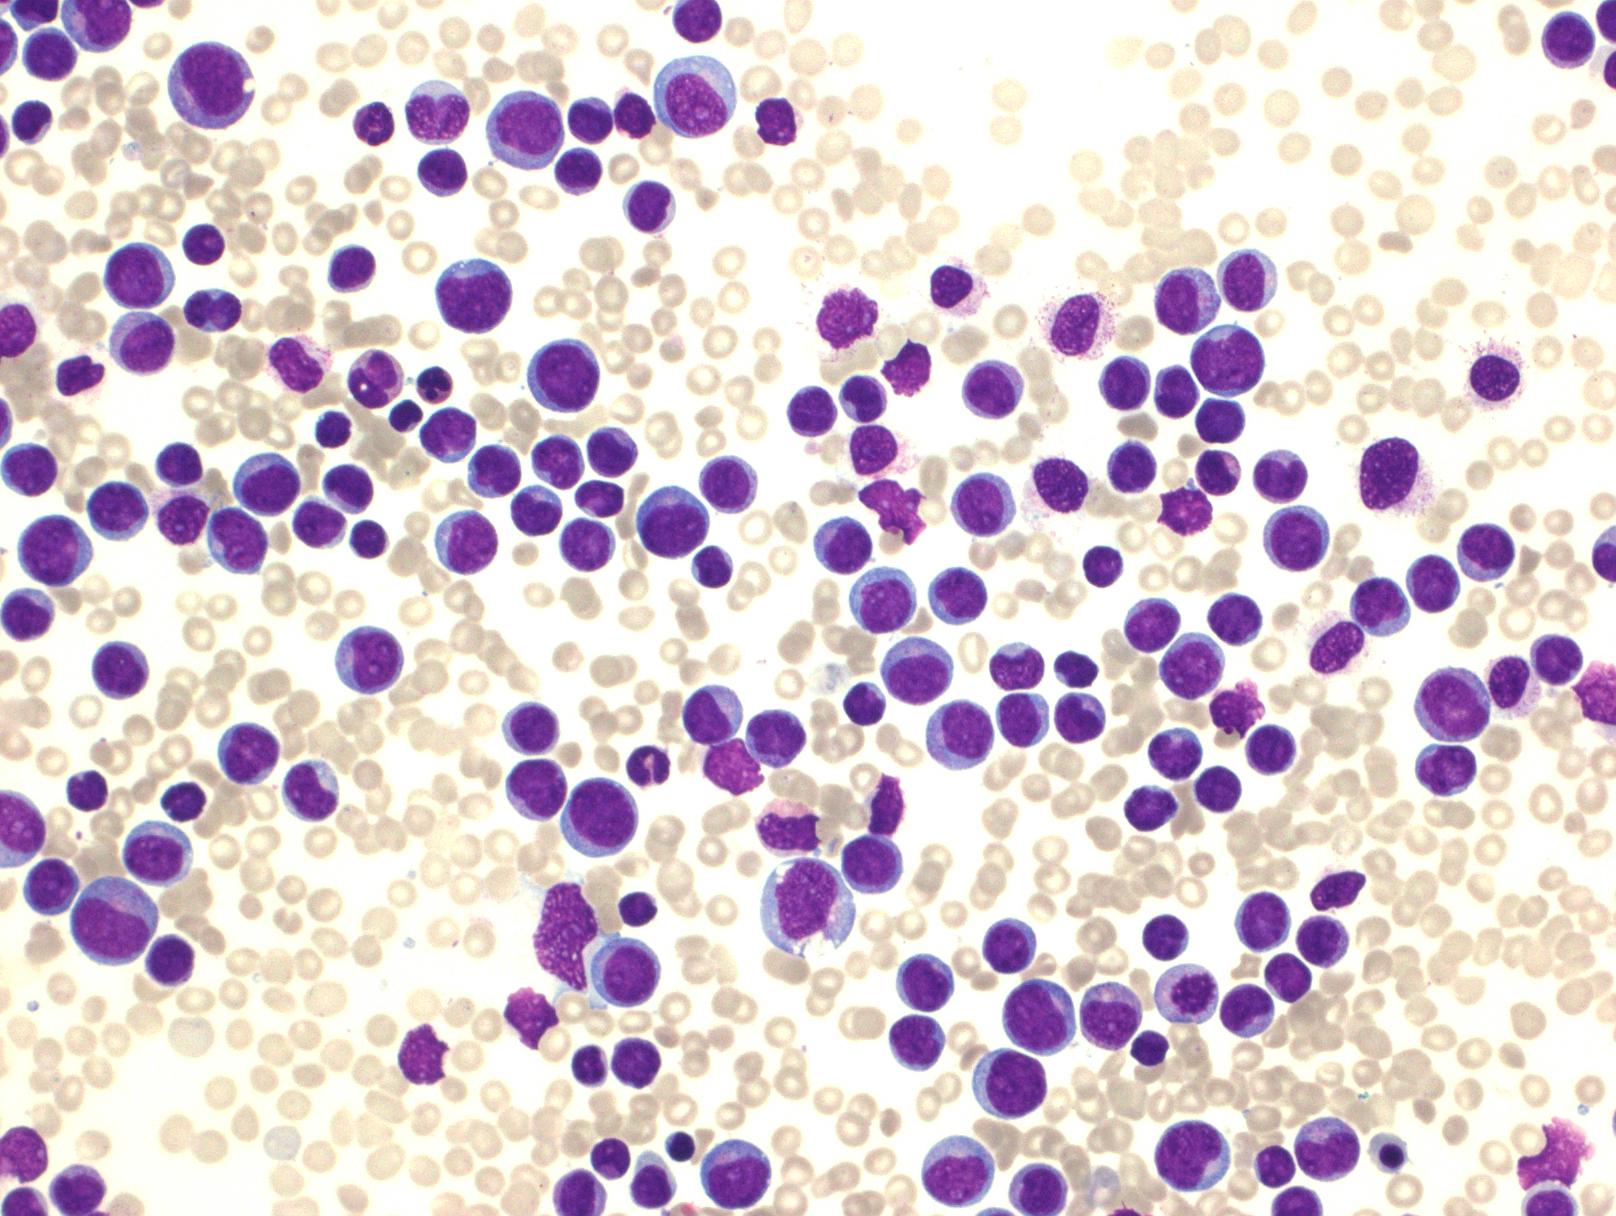
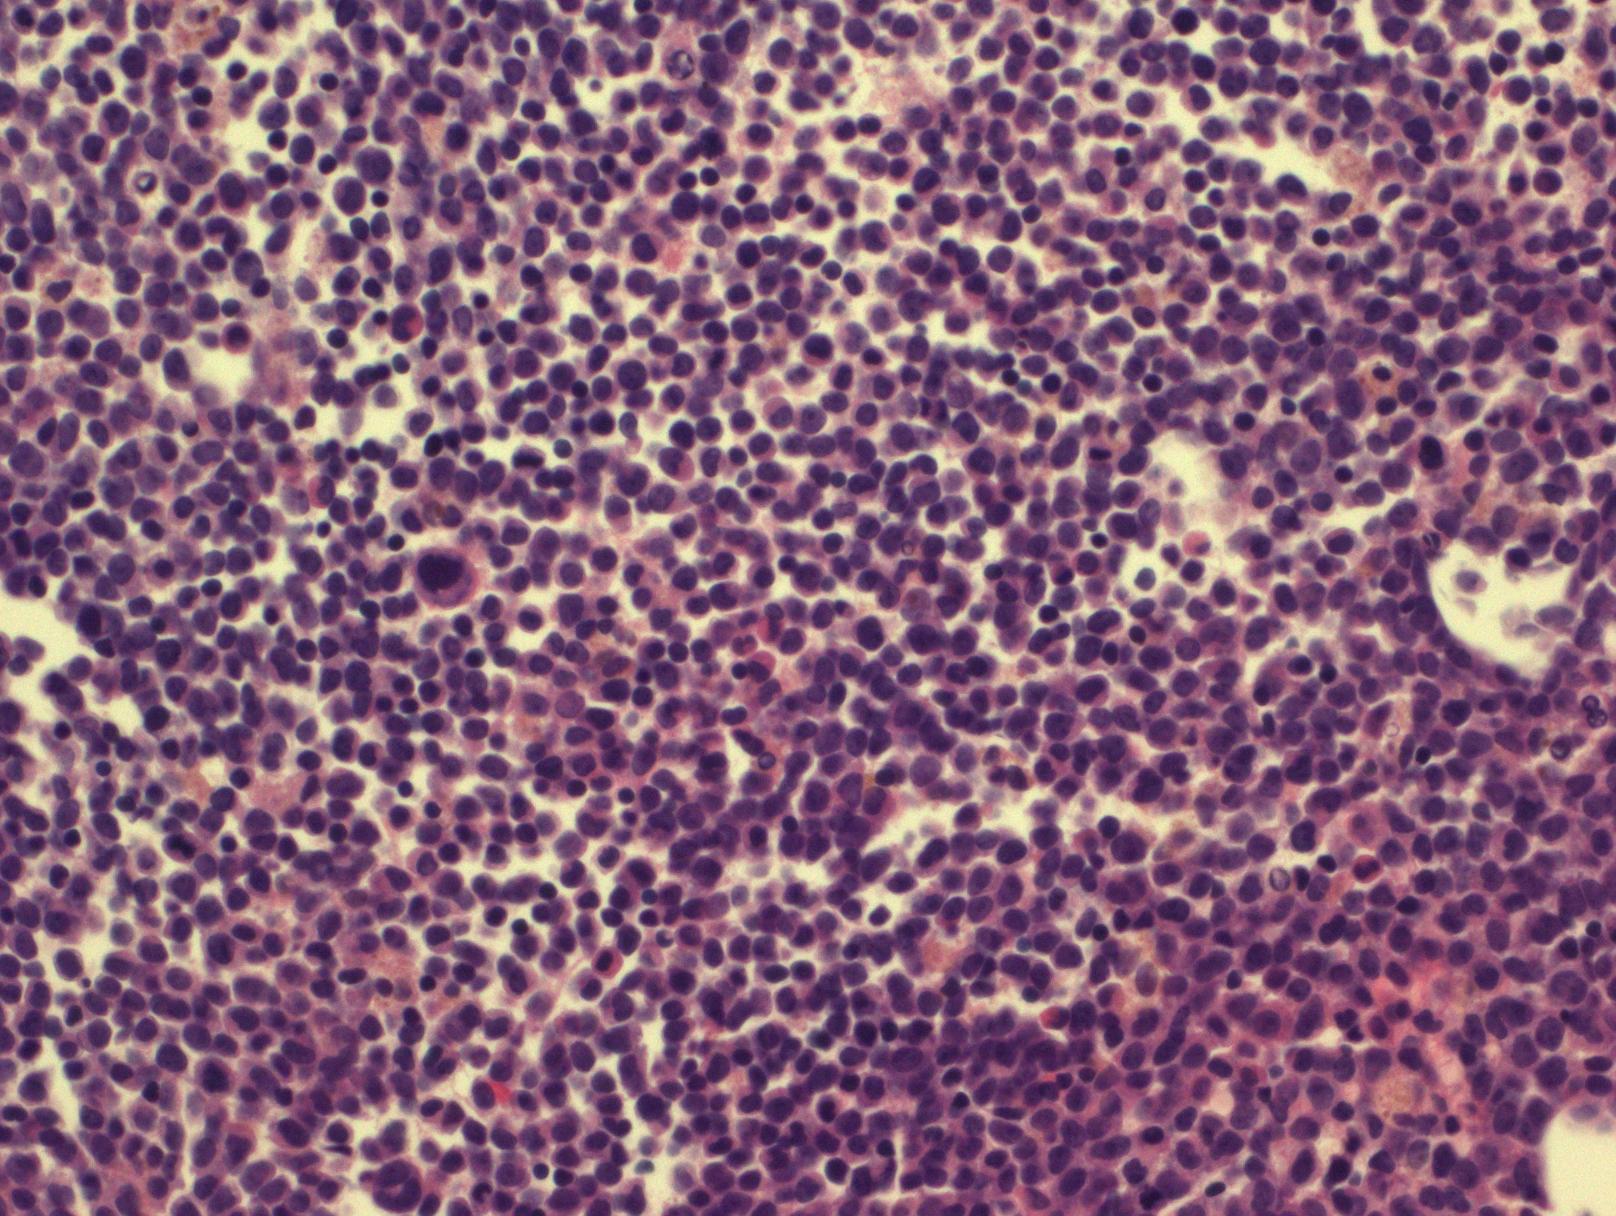

急性粒单细胞白血病
Acute Myelomonocytic Leukemia
概述:
急性粒-单核细胞白血病的特征是中性粒系和单核系同时增生,原始细胞(包括原始粒细胞、原单核细胞和幼单核细胞)总和 ≥20%;而所有单核细胞总和(其中包括原单核和幼单核)应 ≥20%,但 <80%(粒系细胞总和至少 20%)。类似于形态学分类的 FAB M4。不满足 AML 伴重现性遗传学异常、AML 伴骨髓增生异常相关改变和治疗相关 AML 的诊断标准。
诊断要点:
- 占 AML 的 5%-10%,所有年龄都可能发病(中位年龄 50 岁),但多见于老年。常表现为贫血、血小板减少,发热和疲倦。白细胞计数单核细胞增高。
- 细胞形态学:白血病细胞同时具有粒系和单核分化特征。原始细胞成分包括原始粒细胞、原单核细胞和幼单核细胞,相对成熟成分包括粒细胞和异常单核细胞。原单核细胞核大圆形含显著核仁、胞质丰富噬碱、可有少量散在颗粒,幼单核细胞核轮廓较不规则或有轻微折叠、染色质较疏松、核仁小不明显、胞质含细小颗粒,异常单核细胞核明显不规则和折叠、染色质较致密、胞质含颗粒较多。
- 骨髓原始细胞(原始粒细胞、原单核细胞和幼单核细胞) 总和 ≥20%,单核系细胞总和 ≥20% (但 <80%),粒系细胞总和 ≥20%。联合 CAE 和 NSE 染色可帮助识别粒和单核成分。
- 外周血片中单核细胞成分可能比骨髓中更容易识别,分化也更为成熟,其原始细胞成分常较骨髓所见低。因此,骨髓的细胞形态学分类计数对本病的诊断至关重要。
- 免疫表型:常有数群幼稚细胞,不同程度表达 CD13. CD33. CD65. CD15,其中一群幼稚细胞可能表达一些单核细胞分化抗原,如 CD14. CD4. CD11b、CD11c、CD64. CD36. CD68. CD163. LYSOZYME 等;同时表达 CD15 和高表达 CD64 是单核细胞分化的特点。常有一群幼稚细胞表达 CD34 和/或 CD117,多数病例表达 HLA-DR,30%病例表达 CD7。
- 遗传学:可见非特异性的细胞遗传学改变,如+8。

鉴别诊断:
- 慢性粒-单核细胞白血病 :骨髓和外周血原始细胞(包括原始粒、原始单、幼单)计数 <20%,发病较缓慢。合格的骨髓标本和准确的原始细胞/幼单核细胞计数对鉴别至关重要。
- 急性原单核/单核细胞白血病 :骨髓和外周血原单核和幼单核细胞总计数 ≥20%,单核系细胞总计数 ≥80%,粒系细胞成分 <20%。
- 急性髓系白血病伴成熟 :骨髓和外周血原始细胞(≥20%)形态和表型为粒/髓系,单核细胞计数<20%。
